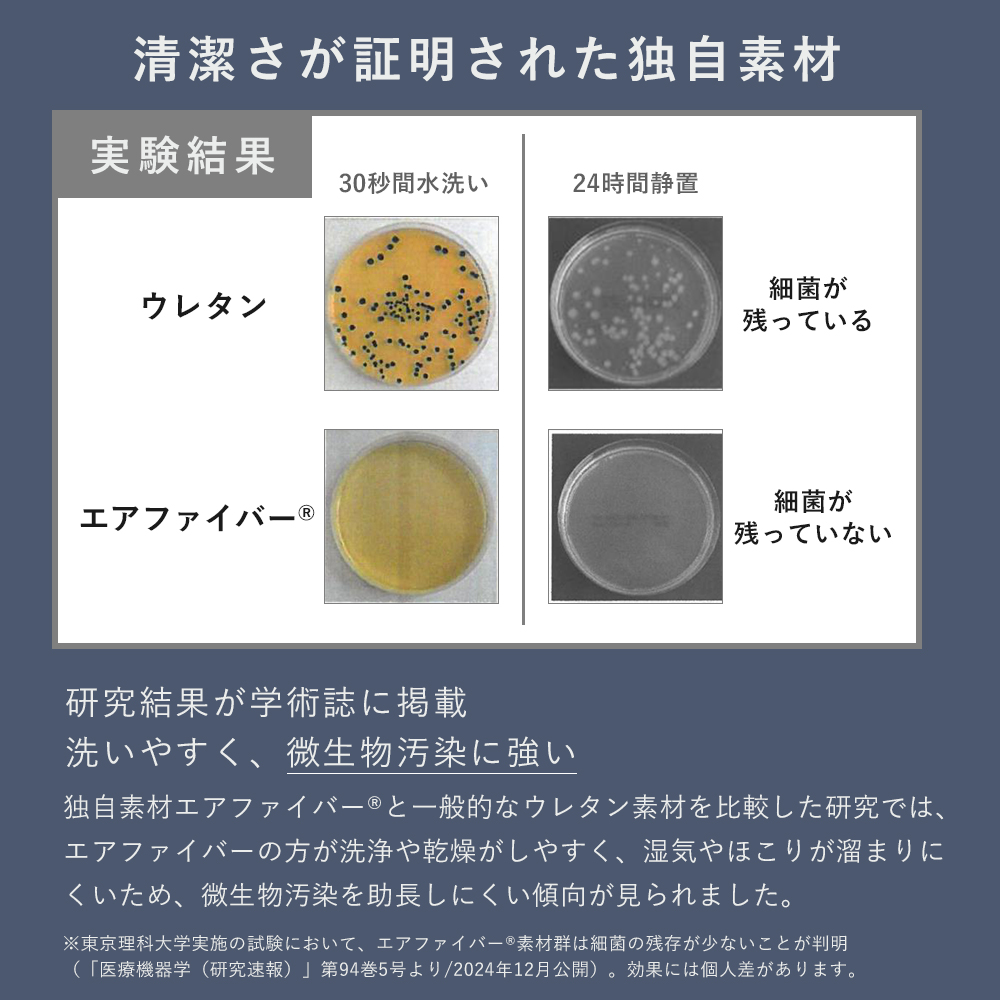

エアウィーヴ スマート Z01 マットレス ダブル ノンスプリングマットレス 三つ折り 折りたたみ 高反発 洗える 腰痛 引っ越し 厚さ9cm エアウィーブ - ショッピング・ショップ | 通販検索
エアウィーヴ スマート Z01 マットレス ダブル ノンスプリングマットレス 三つ折り 折りたたみ 高反発 洗える 腰痛 引っ越し 厚さ9cm エアウィーブ
エアウィーヴ スマート Z01 マットレス ダブル ノンスプリングマットレス 三つ折り 折りたたみ 高反発 洗える 腰痛 引っ越し 厚さ9cm エアウィーブ
この商品は「Yahooショップ」でご購入いただけます。詳しくは下のボタンよりショップサイトへどうぞ。


商品の詳細情報
通気性抜群でお手入れ簡単!大人気三つ折りマットレス

【大人気】寝返りのしやすさ・優れた体圧分散はそのままに、一枚敷き可能な三つ折りマットレス
(1)たっぷりの厚みで身体全体を支える。
中材のエアファバーを贅沢に8センチ使用。底付き感がなく、まるでベッドマットレスに寝ているような寝心地。
(2)お手入れ簡単
人間は寝ている間にコップ1杯分の汗をかくため、寝具はカビ・ダニが発生しやすい場所です。
スマートZ01は定期的に立てかけて風を通すだけでお手入れ簡単。
万が一汚した場合は、丸洗い可能でずっと清潔。
(3)長持ち
肩、腰、脚の部分が三分割になっていて、中材の入れ替えが可能。
身体の中で1番体重のかかる腰部分を入れ替えてご使用することで長持ちできます。
(4)30日間お試し可能
幅 約140cm
長さ 約195cm
厚さ 約9cm(エアファイバー:約8cm)
重さ 約13kg
※3年保証(保証は中材のみ、カバーは初期不良に限ります)
※ベッドフレームの素材や状態によっては破損につながる可能性がございますので、本製品をベッドフレームの上に直接敷くのはお控えください。
エアウィーブ 硬め 三つ折り 折りたたみ マットレス 通気性 高反発 洗える PLAIN


この商品は「Yahooショップ」でご購入いただけます。詳しくは上のボタンよりショップサイトへどうぞ。
価格 : 110,000 円 (税込)



